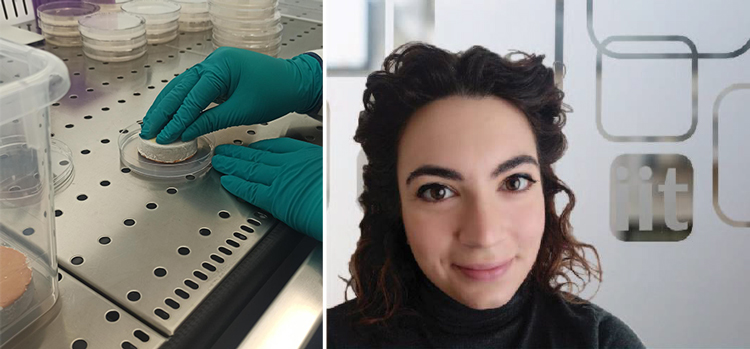

CCHT Team in Amsterdam for CAA 2023!
04/04/2023
The Center for Cultural Heritage Technology Team landed in Amsterdam for the three-day Conference of the Computational Archaeology Association.
Today, in the framework of the EU-funded RITHMS project, coordinated by #CCHT, the session “Hey Google, stop that looter”: digital technologies against cultural heritage crime have seen the contributions of our PI, Dr Arianna Traviglia, Dr Luigi Magnini (Researcher at Università di Sassari), and Dr Michelle Fabiani (Assistant Professor at University of New Haven, College of Criminal Justice and Forensic Science).
In the afternoon, our PhD Candidate, Riccardo Giovanelli presented the talk Disentangle the Net: How Social Network Analysis Can Help Understand and Fight Illicit Trafficking in Antiquities.
In the next few days, the #CCHT team will also present the following papers:
Creating an accurate, well-defined and documented Assyriological Dataset for ML applications: is it for all?
Generalisation Capability of Semantic Segmentation Methods for the Identification of Archaeological Structures on Remote Sensing Data
VHR satellite imagery-based detection of archaeological sites looting in desertic regions via Deep Learning approaches
Envisioning the forthcoming era of robotics and automation in archaeology: a position paper
__________________
About the conference: 2023.caaconference.org
CCHT Team in Amsterdam for CAA 2023!
04/04/2023
The Center for Cultural Heritage Technology Team landed in Amsterdam for the three-day Conference of the Computational Archaeology Association.
Today, in the framework of the EU-funded RITHMS project, coordinated by #CCHT, the session “Hey Google, stop that looter”: digital technologies against cultural heritage crime have seen the contributions of our PI, Dr Arianna Traviglia, Dr Luigi Magnini (Researcher at Università di Sassari), and Dr Michelle Fabiani (Assistant Professor at University of New Haven, College of Criminal Justice and Forensic Science).
In the afternoon, our PhD Candidate, Riccardo Giovanelli presented the talk Disentangle the Net: How Social Network Analysis Can Help Understand and Fight Illicit Trafficking in Antiquities.
In the next few days, the #CCHT team will also present the following papers:
Creating an accurate, well-defined and documented Assyriological Dataset for ML applications: is it for all?
Generalisation Capability of Semantic Segmentation Methods for the Identification of Archaeological Structures on Remote Sensing Data
VHR satellite imagery-based detection of archaeological sites looting in desertic regions via Deep Learning approaches
Envisioning the forthcoming era of robotics and automation in archaeology: a position paper
__________________
About the conference: 2023.caaconference.org
Hunting for microbiological agents: CCHT and INTK together for frescoes conservation
01/10/2022
PhD Candidate at CCHT and Ca' Foscari University with a project on frescoes conservation, Raffaella Lamuraglia is visiting the Institut für Naturwissenschaften und Technologie in der Kunst (INTK, Institute for Natural Sciences and Technology in the Art) of the Akademie der bildenden Künste (Academy of Fine Arts) of Wien for four months under the supervision of Prof. Dr Katja Sterflinger.
INTK's research focuses on colour and perception theory, colour chemistry, materials science, materials ecology and microbiology in art.
While visiting INTK, Raffaella will test the antimicrobial efficiency of new nanostructured formulations developed, in vitro and on fresco mockups, at CCHT Lab on different bacteria and fungi directly sampled on-site in archaeological environments.
Stay tuned on our socials to be updated on this and other ongoing projects!
CCHT featured in RAI program "Newton"
27/06/2022The Center for Cultural Heritage Technology will be featured in the upcoming instalment of RAI program Newton, in the framework of Programma Scienza 2022.
Davide Coero Borga, the scientific communicator hosting the program, meets our PI Arianna Traviglia and IIT researchers Giulia Franceschin and Roberta Zanini to illustrate how innovative technologies can be applied to further the study and boost the protection of Cultural Heritage.
From Earth Observation to Smart Materials, from Hyperspectral Analysis of paintings to ancient glass preservation, the show will explore the research lines active at CCHT and the future challenges.
__________________
On air: 28th June 2022, 9 pm - Rai Scuola
CCHT and V&A team up for glass conservation
01/03/2022
Our PhD Candidate, Roberta Zanini, is spending four months as visiting researcher at the Science Lab of the Victoria&Albert Museum (V&A) under the supervision of Dr Lucia Burgio.
V&A is the world leading museum for applied and decorative Arts and Design. Located in the London city centre, V&A stores collections covering almost any field of Design, from sculpture to textile, from metals to glasses.
Glass and its conservation are the main topics of Roberta's research during her visiting period. In particular, she is trying to understand the relationship between glass composition, storage conditions and conservation issues. Her ultimate goal is to define an analytical protocol, suitable to be used directly by museum conservators, to classify glass types and further define the best conservation condition for each object.
We are thrilled about this new collaboration, keep following our website and social media for more updates!
Welcome to the new Ph.D. students!
01/11/2021
Stefano Centenaro, Neva M. E. Stucchi and Paolo Guzzonato join the Characterization and Protection of Cultural Heritage Materials research group, following the start of a new PhD programme cycle!
Stefano got his Master’s Degree in Materials Engineering at Università di Padova with a thesis on the development of 3D scaffolds mimicking myxoid stroma tumor for testing electrochemotherapy treatments and novel chemotherapy drugs against human breast adenocarcinoma. After, he won a 1-year research grant and acted as research fellow at Università Ca’ Foscari Venezia, studying the chemistry and physics of the Murano’s artistic glass in order to find new strategies for the reuse of artistic glass waste. At our Center, he will work on the artificial simulation of glass degradation phenomena and on the development of protective strategies for the preservation of ancient vitreous materials.
Neva completed her Master’s degree in Conservation Science and Technology for Cultural Heritage at Università Ca’ Foscari Venezia in 2021. Her research thesis aimed to the development and application of silica nanoparticles based consolidants for the conservation of sandstones and concretes. At the CCHT, she will work on synthesis and application of compounds for the conservation of Mosaic tesserae.
Paolo has a Master’s Degree in Sustainable Chemistry and Technologies and he is interested in the development of bio-based smart materials from waste biomass. He addressed this topic in his thesis, focusing mainly on the study of fractionation processes for the valorization of technical lignin. At the CCHT, he will work on the characterization, digitization and protection of ancient manuscripts.
A big welcome to our new colleagues at CCHT!
Our Ph.D. candidates at the Italian Society of Chemistry National Congress 2021
23/09/2021
During the SCI2021 - XXVII National Congress of the Italian Society of Chemistry (Società Italiana di Chimica), our Ph.D. students had the opportunity to share latest updates on their ongoing projects. Raffaella Lamuraglia, Francesco Abate and Roberta Zanini presented their contributions during the works of the ABC Division (Ambiente e Beni Culturali).
Raffaella led the audience on a journey through her findings on frescoes’ technology at the roman time in Aquileia. By combining petrographic (POM) and microchemical (SEM-EDS) analyzes, she was able to identify the supply quarries of raw materials used to make the mortars and a palette of precious inorganic pigments. The interpretation of the results from a historical-artistic and archaeometric point of view made it possible to hypothesize the location of a Roman residential area in the outskirt of Aquileia, providing new starting points for research.
Francesco shared the first results of his investigations on ancient coins. In particular, he showed how a coin covered with thick soil encrustations can be identified without touching it, using X-Ray Tomography and profitably collaborating with archaeologists. He also explained how XRF and FIB-SEM can work together for a modern diagnostic protocol.
Roberta spoke about Laser Ablation (LA) coupled to ICP-MS as a means of obtaining in-depth elemental imaging, depicting how this powerful technique can come in hand for the study of corrosion process on ancient glasses. She explained the potentiality of using the layer-by-layer elemental maps for investigating how the composition of altered glass changes from the bulk to the surface, thus providing information about the kinetic of the corrosion mechanism.SCI2021 represented an incredible opportunity for Italian and foreigner researchers to meet each other, and share ideas and vision, even if virtually.
This 8-days event has involved more than 2000 people, featuring many keynote lectures from distinguished speakers, like the two Nobel Prizes in Chemistry, Roald Hoffmann and Stanley Whittingham.
A bit of CCHT at the first edition of CERN’s Sparks! – The serendipity forum
17/09/2021
The Sparks!Serendipity forum at CERN is an annual two-day multidisciplinary science innovation forum and public event organized by CERN. This year edition was dedicated to Future Intelligence and saw the participation of CCHT director, Dr. Arianna Traviglia.
Sparks! brings together renowned scientists from diverse fields around the world, along with decision makers, representatives of industry, philanthropists, ethicists and the public to bring a novel, multi-faceted approach to addressing some of the big questions of our time.
Sparks! event will become a flagship for CERN's new Science Gateway which is scheduled to open its doors to the public in 2023.
Dr. Traviglia has been invited to share her experience on how technology and humanities can efficiently work together.
For more information and the video replica of the event, please check the Sparks! Forum website.
Robotics, AI and Computer Vision meet Archaeology - RePAIR Project kick-off
01/09/2021
The Center for Cultural Heritage Technology is a partner of the new RePAIR Project, officially started on 1st September 2021
RePAIR stands for ‘Reconstruction the Past: Artificial Intelligence and Robotics meet Cultural Heritage’. The aim of the project is integrating cutting-edge knowledge in robotics, artificial intelligence and 3D digitisation for building a robotic infrastructure for the automated digital scanning, recognition and physical reconstruction of shattered archaeological artefacts.
The robotic system will be experimented at the Pompeii Archaeological Park on the frescoes from the Casa dei Pittori al Lavoro (House of the Painters at work), destroyed during the WW2, and from the Schola Armamentarum.
Beside IIT-CCHT and the Pompeii Archaeological Park, the other partners of the project are: Università Ca’ Foscari Venezia (coordinator), Ben-Gurion University of the Negev (Israel), Associacao do Instituto Superior Tecnico Para a Investigacao e Desenvolvimento (Portugal), Rheinische Friedrich Wilhelms Universitat (Bonn, Germany) and Italian Ministry of Culture. The project has been funded by the Horizon 2020 EU Programme for 3.5M Euros (G.A. n. 964854).
The project has already attracted the attention of national and international newspapers (Le Figaro and Il Sole 24 Ore, among others).
Follow our social media (Twitter and Instagram) to stay update on this and other projects currently running at our center!
Culture & Geopolitics: Dr. Arianna Traviglia at the 2nd Soft Power Conference
31/08/2021
Dr. Arianna Traviglia, CCHT-IIT Director, took part at the 2nd edition of the Soft Power Conference organised by Francesco Rutelli and the association Soft Power Club. The Conference was held on 30th and 31st August in Venice.
Preceded by the official message of the Italian Premier Mario Draghi, enriched by contributions from the President of the European Parliament David Sassoli, the European Commissioner for Economy Paolo Gentiloni, the President of the Italian Senate Elisabetta Casellati, the Italian Minister of Culture Dario Franceschini, and the Italian Minister of Foreign Affairs Luigi Di Maio, this event has taken to the global attention the centrality of the ecological transition and role of culture in the Italian multilateral agenda. The talks of former President of #UNESCO Irina Bokova, the Regional Director at UNESCO Ana Thompson-Flores and General Roberto Riccardi, commander of the Italian #Carabinieri Art Squad, have highlighted the centrality of Soft power for the safeguard of cultural heritage and the sustainable future of #endangered #heritage sites.
The Soft Power Club is an association that aims to define shared messages and pragmatic objectives, placing itself as a forum for maximum inclusiveness, with an international and intercultural scope. The Club boasts numerous members of international importance.
Dr. Traviglia participated as invited speaker for the session The power of Culture and Creative Industries For additional information, check the Soft Power Club website.
Dr. Arianna Traviglia is awarded with 2021 Tecnovisionarie® prize
7/07/2021
We are very proud to announce that our director, Dr. Arianna Traviglia, has won the 2021 Tecnovisionarie® Award.
Tecnovisionarie® is an international prize, which is annually awarded by the Women&Tech association to women that in their professional activity have shown a clear vision in terms of social impact, transparency and ethics.
This year, Tecnovisionarie® awarded a total of 13 women that represent the excellence in the field of Artifical Intelligence. Among them, Arianna Traviglia has been awarded for her pioneristic efforts in the application of Artificial Intelligence to Cultural Heritage.
During the ceremony, held online on June 10th, the prize has been ‘virtually’ delivered to Arianna by Dr. Barbara Gallavotti, biologist, scientific journalist and science communicator, part of the scientific committee of di Museo Nazionale Scienza e Tecnologia and author of the popular tv program Superquark.
For this special occasion, Rainews24 (the main italian all-news tv channel) dedicated a personal interview to our director. You can watch it HERE.
For more information about the prize and its current and past winners, please visit tecnovisionarie.eu.
Dr. Artesani and Dr. Ljubenovic participated at the Virtual SPIE O3A Conference
21-25/06/2021
Dr. Alessia Artesani and Dr. Marina Ljubenovic partecipated as speaker at the SPIE O3A Conference.
During the live sessions of the virtual conferences, Alessia discussed the results of Terahertz Time-Domain Spectroscopy (THz-TDS) imaging carried out on cultural heritage assets. Hyperspectral THz images are corrupted by several degradation effects and their processing pose therefore major challenges. In this work, the limits of THz-TDS are addressed by a twofold computational strategy: (i) removal of the surface warping and (ii) application of a fast joint deblurring-denoising approach for image restoration. The reduction of the main degradation effects is illustrated with the aid of experiments conducted on ancient silver coin and a contemporary painting, highlighting the advantages for cultural heritage applications of imaging spectroscopy in the far-infrared frequencies.
Marina introduced a novel fast hyperspectral image deblurring and denoising approach tailored to archaeological applications of remote sensing. Hyperspectral data (recorded by means of airborne or satelliteborne sensors and used to detect buried archaeological deposits) often lack in spatial resolution and contains blurring degradation and noise. The methodology here presented is based on the low-rank properties of hyperspectral images and exploits a sparse data representation linked with the self-similarity characteristics of image patches. As a result, noise belonging to different spectral regions is removed and the spatial resolution of bands increased, thus significantly improving the possibility of detection of yet-unknown buried archaeological sites.
Check out the registered presentations and the conference proceeding at:
"Processing and analysis of THz time-domain spectroscopy imaging applied to cultural heritage"